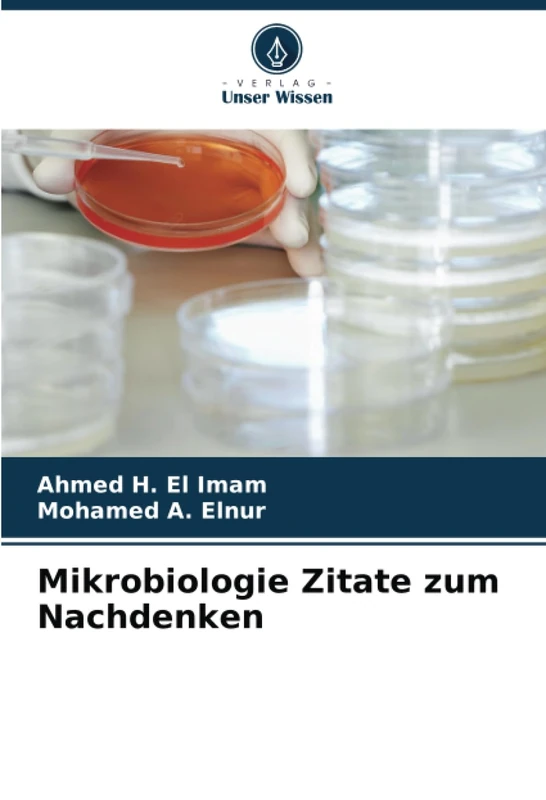
Mikrobiologie Zitate zum Nachdenken

We can't find the internet
Attempting to reconnect
Something went wrong!
Hang in there while we get back on track

£55.00
General Microbiology: Course and comprehension questions
Price data last checked 104 day(s) ago - refreshing...
We'll watch every seller, every day. One email when your price arrives.
It has never been this cheap. We have no record of a lower price.
£55 today · cheaper than every other day in the last 12 months
NEW HERE?
Amazon shows you one price. We show you all of them.
Tosheroon watches Amazon prices so you don't have to. Every product on Amazon has a price history — we make it visible. Set the price you'd actually pay, and we'll email you the second it gets there. No app, no account, one email.
WHAT'S ON THIS PAGE
when this has been cheap or pricey
where the price is heading next
all-time high & low, recent range
name your number, we'll email you
Price History & Forecast
Grey patches = out of stock. Cheaper = lower on the chart. Hover for exact prices.
Last 264 days • 264 data points (No recent data available)
Price Distribution
Price distribution over 264 days • 1 price levels
Price Analysis
Most common price: £55 (264 days, 100.0%)
Price range: £55 - £55
Price levels: 1 different prices over 264 days
Product Specifications
- Format
- paperback
- ASIN
- 6205220997
- Domain
- Amazon UK
- Release Date
- 03 October 2022
- Listed Since
- 04 October 2022
Barcode
No barcode data available
Similar Products You Might Like

Konzept der praktischen Bakteriologie

Lehrbuch der Mikrobiologie: Mikrobiologie
Mikrobiologie Zitate zum Nachdenken

Buccofacial Septic Processes: Infections

Classroom climate: a look at PUJ English courses: Classroom Climate and Second Language Acquisition

Banking litigation in the CEMAC zone

Genpolymorphismen bei Mikroorganismen

Company accounting in OHADA

Das native Profil häufiger gramnegativer bakterieller Krankheitserreger: Mikrobiologie

Modeling and Simulation of Complex Systems

Hygiene in Lebensmittelbetrieben

INDUSTRIAL ECOLOGY

Air law brief: International air services

Intercultural competence in tour guides: intercultural competence in tour guides

NEUROPICHOLINGUISTICS

Intercultural Education and English Language Teaching Policies: Ethnographic Scenes in Peru

Intercultural communication practice in travel writing

Socio-cultural values and vendor performance

Internal audit of electronic banking operations in the banking sector

Costing, pricing and hospital financing

Environmental Media: Analysis of imethetic-discursive patterns

THE REFERENCE OF FUNDAMENTAL QUESTIONS OF GEOPOLITICS: Course Notes
THERAPEUTIC BIONANOCOMPOSITES
